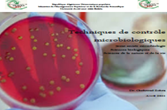

**صدور تحديث جديد للتصنيف الدولي Scimago Institutions Rankings لطبعة 2023****مراسم التوقيع لإعتماد إنشاء ملحقة الطب بجامعة سكيكدة -هنيئا لجامعتنا*** برنامج السهرات العلمية الرمضانية "ستارت أب" Start up لجهة الشرق ***نداء للأساتذة للمشاركة في استبيان الأكادميين لدعم ترتيب الجامعة في تصنيف World University Rankings QS*****الإنطلاق الرسمي للتكوين في الدكتوراه بعنوان السنة الجامعية 2022/2023 بجامعة سكيكدة **** فعاليات النشاط الإفتتاحي لأسبوع القرآن الكريم**** تنظيم أسبوع الذكاء الإصطناعي من 16 إلى 19 أفريل 2023
Contactez nous
Adresse géographique: Université 20 Août 1955
BP 26. Route d'El Hadaiek-Skikda 21000 – Algérie.
E-Mail: Cette adresse e-mail est protégée contre les robots spammeurs. Vous devez activer le JavaScript pour la visualiser.
Tél: +213 38723183

.png)











